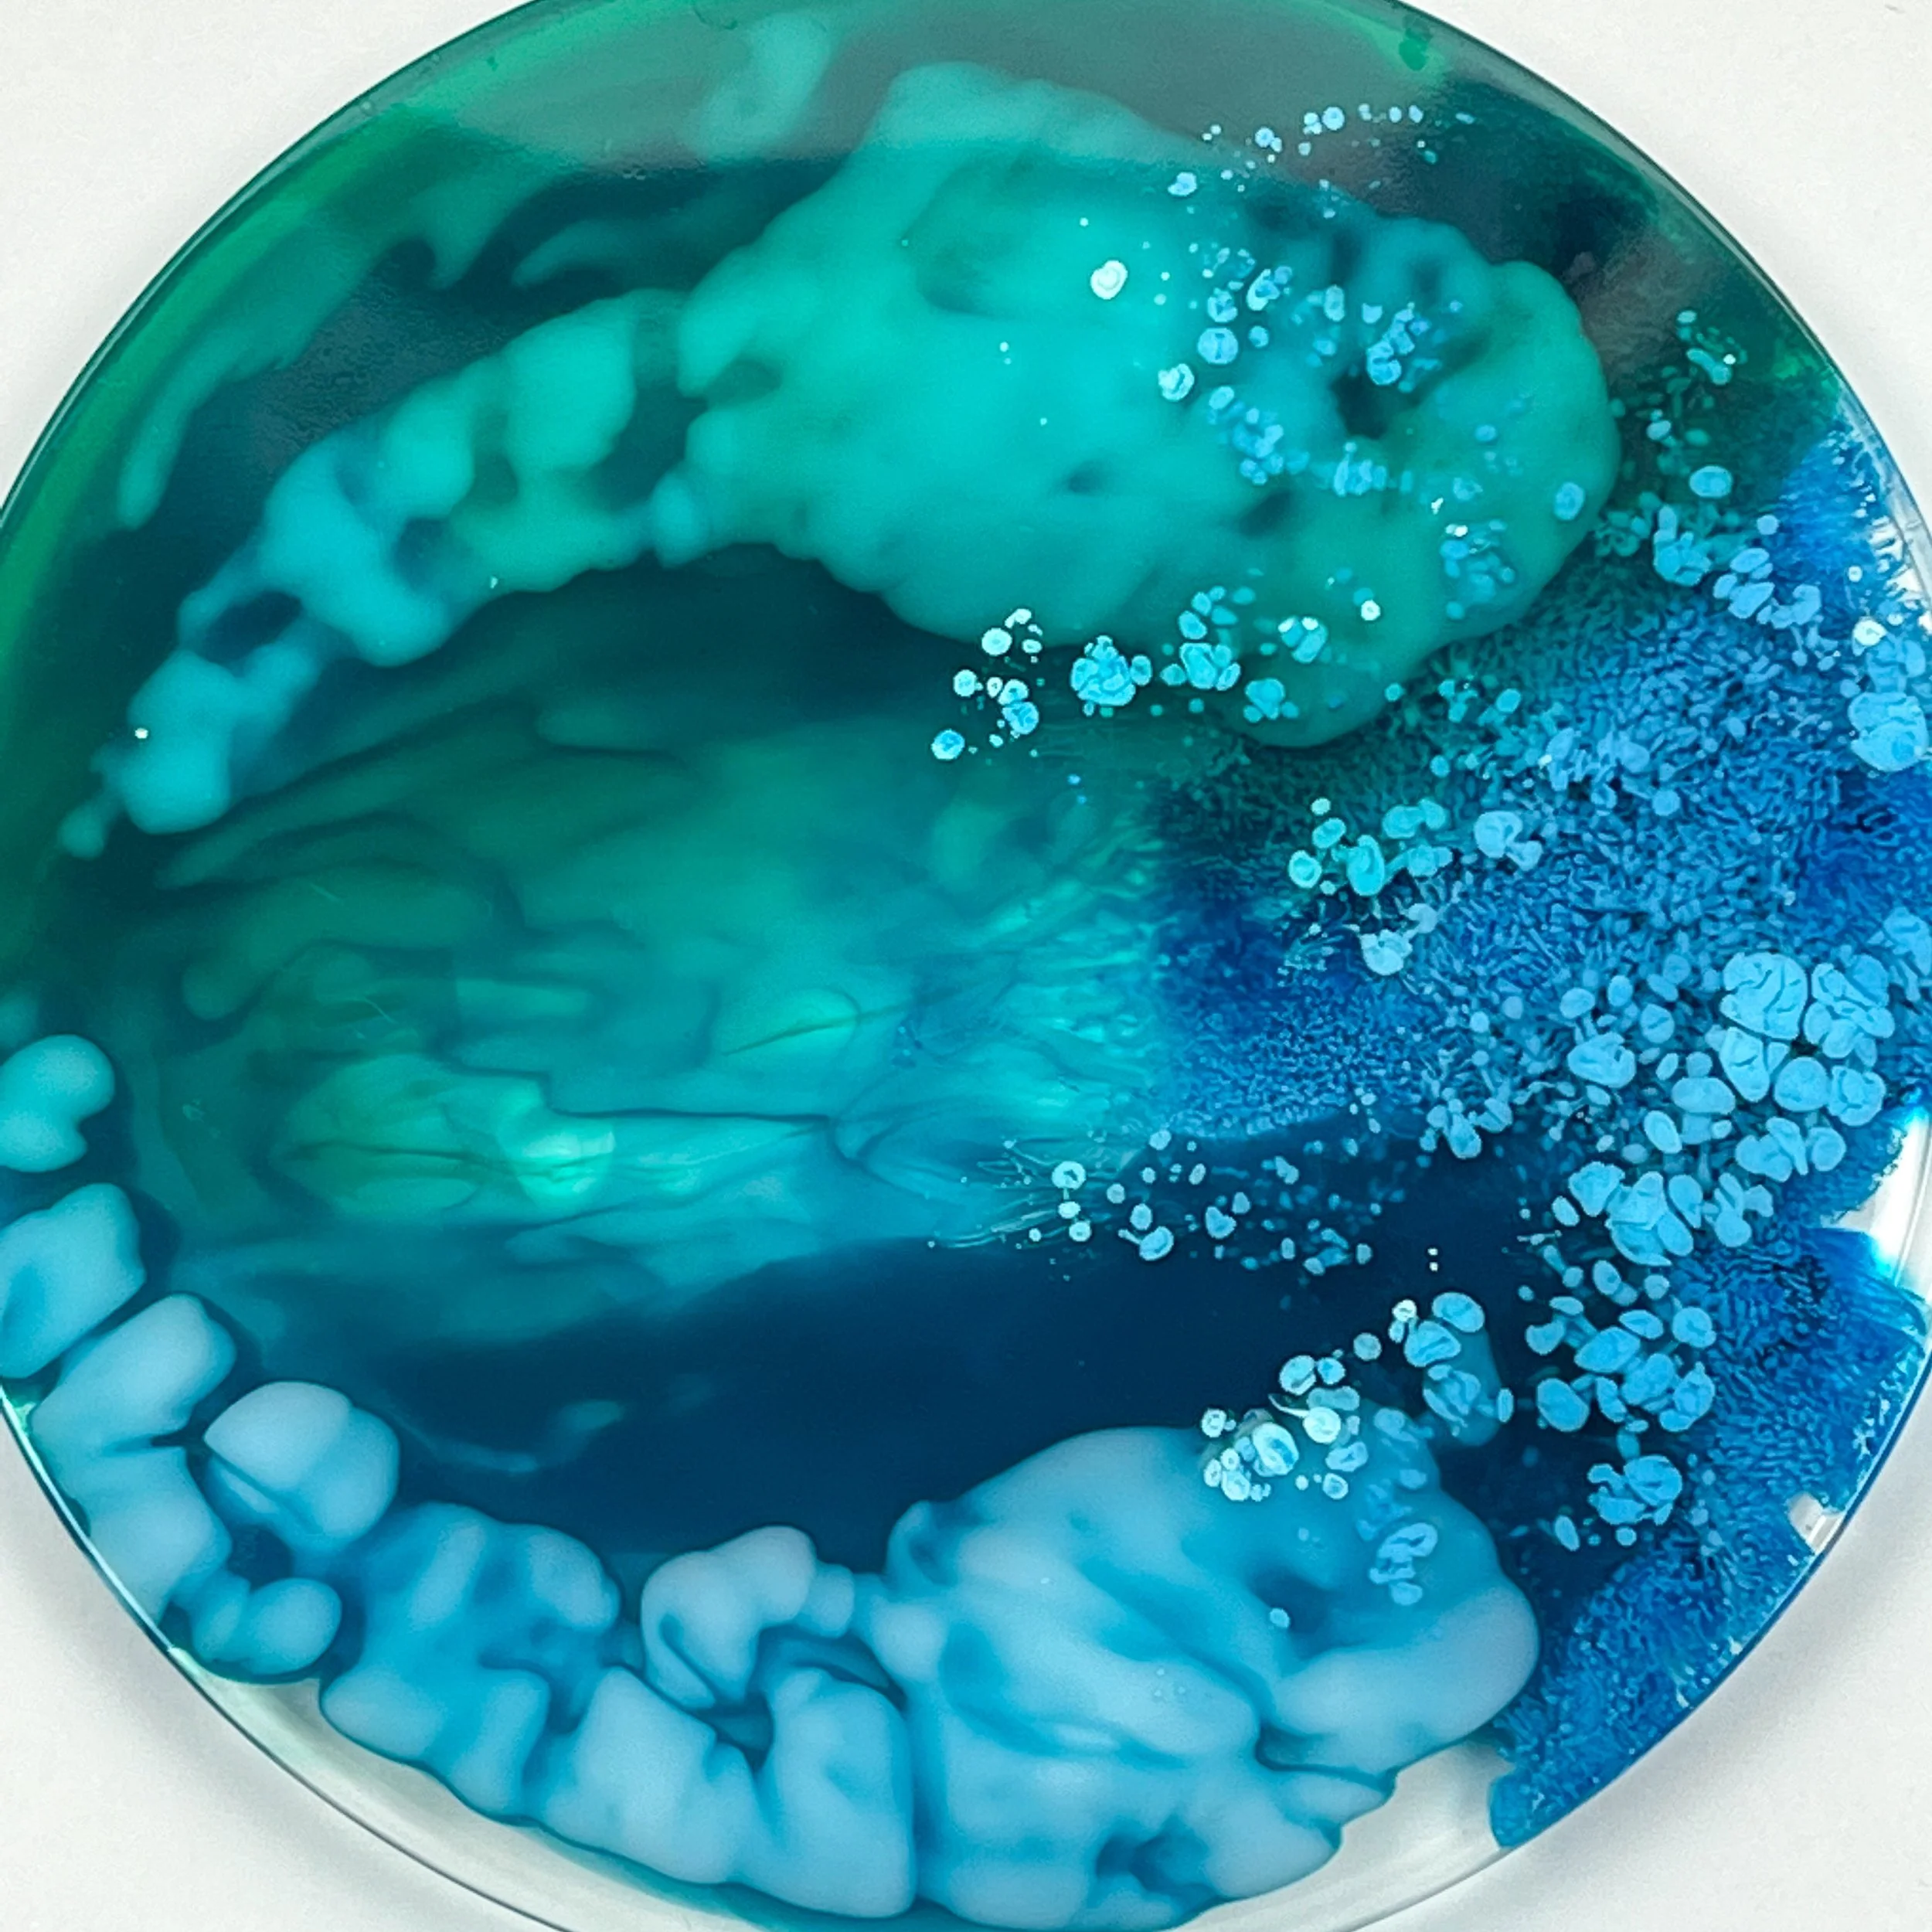

Resin Coaster Workshop Dubai
with professional artist Marlis Dsouza
Unleash your creativity in a fun, beginner-friendly session where you’ll create 2 resin coasters.
This is an on-demand private workshop, perfect for a solo creative session or a fun group activity with up to 6 people
🕐 1-hour session | 📍 Dubai South | 👩🏼🎨 All supplies included | AED 370 per person
*exact location shared after booking
What You’ll Experience
Step-by-step guidance – Dive into the dazzling world of resin casting! You’ll learn how to cast resin in a silicone mold lead by professional artist Marlis Dsouza (no experience needed).
Create your masterpiece – You’ll create not just one, but two awesome coasters during our session.
Hands-on fun – Play with resin, pigments, mica powders and alcohol inks techniques. Best part is that after the workshop you can apply the same technique to craft magnets, pendants, trays, bookmarks, and countless other creations!
What’s Included
All art supplies to create 2 resin coasters (resin, silicone mold, pigments, gloves, apron, etc).
Your coasters, once cured (dried) and delivered within a week.

Testimonials
-
Marlis is a great instructor and learning how to make resin coasters was fun!
- Majdel
-
Marlis is so thorough with her explanations and walks you through every step of why, how and when things are done. It’s very interactive and engaging. Would highly recommend to all!
- Nadine
Good to Know
-
All bookings are non-refundable. Each workshop is planned with a specific number of participants in mind, so cancellations will not be reimbursed.
If you are unable to attend, you may transfer your spot to a friend by emailing me (studio@artsybym.com) at least 24 hours before the event
In the rare case that the workshop is canceled by me (due to unforeseen circumstances), you will be offered the option to reschedule for a future session.
No-shows will not receive a refund or credit for future workshops.
-
There will be photography and video recording during the workshop.
If you do not consent to being photographed, please notify me before the workshop begins.
-
Due to the resin curing (drying) process, your coasters will not be ready to take home immediately. They will be safely boxed and delivered to your preferred address.
-
I recommend avoiding long sleeves and wearing clothes you don’t mind getting messy.
All necessary materials, including gloves and apron, will be provided.
This workshop involves fluid art techniques, so expect a hands-on, interactive, and potentially messy experience!
-
My home studio is located in Dubai South. The exact location will be shared after the booking is made.
There is free parking in the vicinity.
-
This workshop is for participants 16 years and older.
How it works
💳 STEP 1
Book your spot
Click “Book Now” and complete your payment securely through Stripe.
At checkout, you’ll be able to share your preferred date and time for the workshop.
📅 STEP 2
Confirm your time
Once your booking is complete, I’ll personally contact you within 24 hours by WhatsApp/email to confirm your slot.
🎨 STEP 3
Create your coasters
Arrive at my Dubai South studio, relax, and enjoy your hands-on workshop!
(Exact location will be shared once your booking is confirmed.)
Feel free to contact me if you have any questions or would like to host a workshop like this one at another venue or with a larger group.


